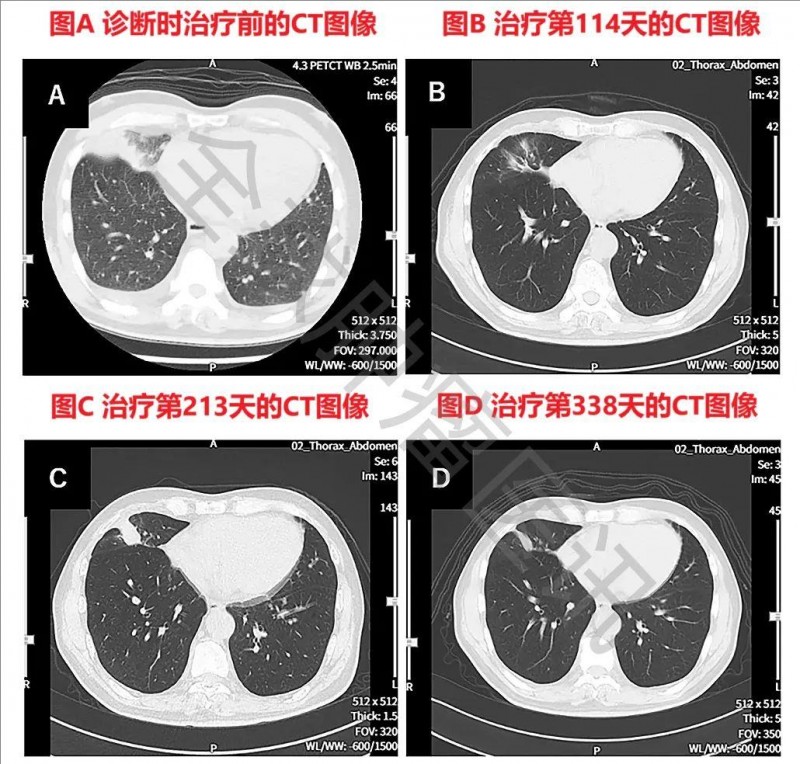

四年未复发奇迹!我国十款树突状细胞疫苗新药IND获批,重拳出击肺癌、肠癌、卵巢癌等
我国十种树突状细胞(DC)疫苗新药临床试验获批,重拳出击肺癌、肠癌、卵巢癌等
DC细胞作为关键的前哨细胞,于肿瘤免疫进程中占据着举足轻重的地位。尤其是2011年诺贝尔生理学或医学奖得主拉尔夫·M·斯坦曼(Ralph M. Steinman)揭示树突状细胞(dendritic cell,DC)及其在获得性免疫应答里的核心作用后,全球范围内随即掀起了对DC肿瘤疫苗的研究热潮。
值得欣慰的是,近年来国内DC细胞治疗行业也呈迅猛发展之势,一系列临床试验正如火如荼地推进,据国家药品监督管理局药品审评中心(NMPA)官网消息,目前我国已有10种DC疫苗的新药临床试验申请(IND)获批(详见下图)!可以预见,在不久的将来,我国于这一治疗领域必将达成从追随到引领的跨越性发展,实现从跟跑者到领跑者的华丽转身,在全球肿瘤治疗领域绽放出更为耀眼的光芒,为更多患者带来更多的希望与选择。
何谓树突状细胞
树突状细胞(dendriticcell,DC)为一类多功能抗原提呈细胞,通过DC上的主要组织相容性复合体(MHC)分子,与T细胞上的T细胞受体之间的相互作用,以及共刺激分子来调节免疫反应。研究者利用树突状细胞对抗原的摄取和呈递,来挖掘其抗癌潜力。特别是,树突状细胞具有向CTL和T辅助淋巴细胞交叉呈递抗原的潜力,因此,可被用作刺激细胞毒性抗肿瘤免疫反应的疫苗。
而树突状细胞疫苗(DC疫苗)就是将从癌症患者身上提取的树突状细胞 (DC),负载上某种 TAA 来源,然后再输回患者体内的一种治疗方法。制备自体DC疫苗的主要过程如下:
→第一步,首先抽取患者的外周血,然后从血液样本中提取未成熟的DC或单核细胞。
→第二步,制备患者自身肿瘤组织裂解物,提取的细胞通常在体外加载肿瘤裂解物、肿瘤相关抗原 (TAA) 或新抗原;
→第三步,将成熟的DC,回输到患者体内,以产生肿瘤特异性效应T细胞反应。相当于与对免疫系统下达“消灭指令”,使免疫细胞能精准识别,并杀灭这类带有特异性抗原的“癌细胞”(详见下图)。

▲图源“ScienceDirect”,版权归原作者所有,如无意中侵犯了知识产权,请联系我们删除
NMPA批准的十款DC疫苗新药IND

▲截图源自“NMPA”
晚期十二指肠癌患者经WT1/MUC1-DC联合CAT治疗后,恶性腹水消失,肿瘤52个月未进展
十二指肠癌为非壶腹部的十二指肠恶性肿瘤,虽然仅占所有胃肠道癌症的0.3%~0.5%,但却是一种高度侵袭性的癌症,会在小肠内迅速扩散。根治性切除是唯一可能治愈的方法,对于无法切除的十二指肠癌通常采用化疗方案,但由于缺乏针对十二指肠癌的特异性化疗方案,加之目前尚无针对恶性腹水的有效治疗方法,因此很多患者预后不理想,故而迫切需要开发增强抗肿瘤免疫系统的治疗策略。
近年,随着树突状细胞疫苗,尤其是WT1树突状细胞疫苗(WT1-DC)的出现,为这类患者带来了一线转机。WT1-DC疫苗是根据人类白细胞抗原(HLA)检测结果,将适合患者的WT1肽(日本树突状细胞疫苗的常用抗原,在多类肿瘤中高表达),掺入培养的树突状细胞中,制备与患者HLA相容且疗效更好的“定制版”树突状疫苗,可用于实体瘤及血液肿瘤的治疗。据美国国家癌症研究所报告,Wilms肿瘤1(WT1)、粘蛋白1(MUC1)分别是最理想和第二理想的免疫原性TAA。因此,使用用WT1和MUC1肽脉冲的树突状细胞(WT1/MUC1-DC)的疫苗可能代表一系列癌症的可行且微创的治疗选择。
全球知名医学杂志《Cureus》报道了一个“十二指肠癌腹膜播散和恶性腹水患者,经WT1/MUC1-DC联合CAT治疗后,腹水消失且肿瘤52个月(≈4.3年)未进展”的惊艳案例。该患者是一位72岁的日本男性,确诊为原发性十二指肠癌(IV 期:T3N2M1),十二指肠肿瘤活检结果诊断为腺癌,并伴有远端淋巴结转移。既往在胃空肠旁路手术后,接受了S-1(一种口服嘧啶氟化物衍生药物)+奥沙利铂化疗,虽然肿瘤缩小,但却发生了腹膜播散。后续尽管采用了包括伊立替康的二线化疗方案,但腹膜播散、恶性腹水和恶病质在给药第二个月迅速进展,腹部CT显示大量恶性腹水和十二指肠周围大网膜脏脂肪征(详见下图),最终导致化疗失败。
▼该患者DC联合CAT治疗前腹部CT

▲图源“Cureus”,版权归原作者所有,如无意中侵犯了知识产权,请联系我们删除
注:
①图A:十二指肠周围可见明显扩张的大网膜(箭头所示)。
②图B、C:因十二指肠癌扩散而出现大量腹水。
此时临床已经没有适合他的治疗方法了,遂入组接受了WT1/MUC1-DC(WT1和MUC1肽脉冲树突状细胞)+CD3激活T淋巴细胞(CAT)的过继细胞疗法(ACT)治疗。2020 年 1 月,该患者开始接受WT1/MUC1-DC+CAT治疗)。患者在第6次治疗后,该症状明显改善。最终在第8次治疗后1个月,患者症状和癌症周围的恶性腹水都消失了。具体表现为腹胀、腿部水肿完全消失,食欲完全恢复,原发病灶和转移性淋巴结的缩小持续存在,腹膜播散的影像学表现在CT上不再明显(详见下图)。
值得一提的是,该患者在治疗中未出现治疗相关严重副作用,且能够恢复正常活动,每隔几个月继续接受这种治疗作为维持治疗,迄今为止,该患者给药后至少54个月没有出现恶性腹水。
▼该患者DC联合CAT治疗后腹部CT

▲图源“Cureus”,版权归原作者所有,如无意中侵犯了知识产权,请联系我们删除
注:
①图A:腹腔内脂肪性粘稠组织大网膜已不可见。
②图B:十二指肠癌播散引起的腹水已消退。
③图C:大量腹水导致腹压形成的右侧腹股沟疝持续存在。
肺癌全身转移患者WT1-DC与化疗联合治疗后,无进展生存期超577天
WT1树突状细胞疫苗(WT1-DC)除了治疗肠癌外,还可用于肺癌的治疗。《Cureus》杂志近期还报道了一个“WT1-DC治疗复发性和多发性肺癌全身转移患者,无进展生存超577天”的案例!
该患者为一位69岁男性右肺中叶IV期鳞状细胞癌患者,同时伴多发性骨转移、多发性肝转移、双侧肾上腺转移等症状。此时,该患者的情况已无法耐受手术及放射治疗,遂入组接受WT1树突状细胞疫苗(WT1-DC)联合化疗(方案为卡铂AUC6+紫杉醇)治疗。
结果显示:该患者无进展生存期(PFS)>577天,体能状态为1,临床状况良好,可正常生活。癌胚抗原(CEA)持续升高,但在联合雷莫芦单抗+多西他赛后,CEA降至5.9。
1、全身转移灶改善:该患者在治疗前,全身PET-CT可见右下肺原发肿瘤,同时伴多发性双侧肺内转移、多发性肝转移、双侧肾上腺转移、多发性骨转移等全身转移灶。但在WT1-DC治疗第479天复查PET-CT显示,全身转移灶明显改善,除右肺转移病灶(直径为1.0cm)、肝脏转移病灶(直径为1.7cm)外,未见其他转移灶(详见下图)。
▼该患者WT1-DC治疗前后全身PET-CT对比

▲图源“Cureus”,版权归原作者所有,如无意中侵犯了知识产权,请联系我们删除
2、原发灶及复发病灶缩小:该患者确诊时胸部CT可见右下肺原发性肺癌,同时伴左右胸腔积液;在WT1-DC治疗后第114天,肺部原发病灶几乎消失;在治疗第213天,虽然原发病灶有一定程度的复发;但在治疗第338天,原发性及复发性病灶缩小(详见下图)。
▼该患者WT1-DC治疗前后胸部CT图像对比
▲图源“Cureus”,版权归原作者所有,如无意中侵犯了知识产权,请联系我们删除
想寻求DC疫苗或个性化癌症疫苗帮助的患者,可将近期病理报告、出院小结、治疗经历等资料,提交至医学部,进行初步评估。
树突状细胞联合二线化疗,卵巢癌总生存期显著提升13.4个月
一项“应用DCVAC/OvCa(树突状细胞疫苗)联合二线化疗,治疗铂敏感型卵巢癌的2期临床研究(NCT02107950)”,共入组71例患者,将其随机分为两组,即DCVAC/OvCa组(n=39,接受DCVAC/OvCa联合化疗)、对照组(n=32,单独接受化疗)。结果显示如下:
1、客观缓解率(ORR):DCVAC/OvCa组的ORR高达87.5%(95% CI 71.0–96.5),而对照组仅为62.5%(95% CI 43.7–78.9)。
2、中位总生存期(OS):DCVAC/OvCa 组的中位OS显著延长13.4个月,分别为35.5个月(DCVAC/OvCa组) vs 22.1个月(对照组)(详见下图)。

▲图源“Gynecologic Oncology”,版权归原作者所有,如无意中侵犯了知识产权,请联系我们删除
3、中位无进展生存期(PFS):中位PFS分别为11.3个月(DCVAC/OvCa组) vs 9.5个月(对照组)(详见下图)。

▲图源“Gynecologic Oncology”,版权归原作者所有,如无意中侵犯了知识产权,请联系我们删除
小编寄语
癌症作为一种高度突变的复杂疾病,很难仅靠单一治疗手段,达到理想的治疗效果。目前比较理想的治疗手段是在权威医院(手术、放化疗等)传统治疗的基础上,结合患者病情、个体情况,突变靶点、经济状况等,辅助靶向药、免疫细胞治疗(如CAR-T、TCR-T、TIL细胞疗法、DC疫苗)、质子治疗、电场疗法等新型治疗手段,以达到巩固传统治疗效果、降低肿瘤复发风险、提高患者生存质量、延长生存期等目的。
其中,树突状细胞(DC)作为唯一能激活初始T细胞的抗原提呈细胞,在机体免疫中发挥着重要的作用,而DC疫苗就是利用其独特的免疫特性,来治疗癌症的方法!对目前治疗方案不满意,或想寻求树突状细胞疫苗等抗癌新技术帮助的患者,可将近期病理报告、影像学检查资料、治疗经历等,提交至医学部,进行初步评估。
参考资料
[1]Yagawa Y,et al.Peritoneal Dissemination and Malignant Ascites in Duodenal Cancer Successfully Treated With Adoptive Cell Therapy Using WT1-and MUC1-Pulsed Dendritic Cells and Activated T Cells With No Adverse Effects: A Case Report[J]. Cureus, 2024, 16(11).
https://www.cureus.com/articles/308954-peritoneal-dissemination-and-malignant-ascites-in-duodenal-cancer-successfully-treated-with-adoptive-cell-therapy-using-wt1--and-muc1-pulsed-dendritic-cells-and-activated-t-cells-with-no-adverse-effects-a-case-report#!/
[2]Nagai H,et al.WT1 Dendritic Cell Vaccine Therapy Improves Immune Profile and Prolongs Progression-Free Survival in End-Stage Lung Cancer[J].Cureus,2023,15(10).
https://www.cureus.com/articles/193305-wt1-dendritic-cell-vaccine-therapy-improves-immune-profile-and-prolongs-progression-free-survival-in-end-stage-lung-cancer#!/
[3]Cibula D,et al.Dendritic cell-based immunotherapy (DCVAC/OvCa) combined with second-line chemotherapy in platinum-sensitive ovarian cancer (SOV02): A randomized, open-label, phase 2 trial[J]. Gynecologic Oncology, 2021, 162(3): 652-660.
https://www.gynecologiconcology-online.net/article/S0090-8258(21)00533-3/fulltext
扫描进患者病友群
肺癌|胃癌|肝癌|结直肠癌|胰腺癌
乳腺癌|脑瘤|淋巴瘤|儿童肿瘤等
相关推荐
【PD-1抑制剂免费招募】新一代靶向药H
EGFR突变型患者在非小细胞肺癌中约占30%,在欧美患者中约占10%~20%,在亚洲患者中占比超过50%,是非小细胞肺癌的第二大致癌驱动因素。...
全球肿瘤医生网 2020-08-05
初战告捷!CAR-NK首次人体试验,60
EGFR突变型患者在非小细胞肺癌中约占30%,在欧美患者中约占10%~20%,在亚洲患者中占比超过50%,是非小细胞肺癌的第二大致癌驱动因素。...
全球肿瘤医生网 2020-08-05
"盔甲式"CAR-T
EGFR突变型患者在非小细胞肺癌中约占30%,在欧美患者中约占10%~20%,在亚洲患者中占比超过50%,是非小细胞肺癌的第二大致癌驱动因素。...
全球肿瘤医生网 2020-08-05
肠癌患者迎来免疫新"杀手&qu
EGFR突变型患者在非小细胞肺癌中约占30%,在欧美患者中约占10%~20%,在亚洲患者中占比超过50%,是非小细胞肺癌的第二大致癌驱动因素。...
全球肿瘤医生网 2020-08-05
晚期非小细胞肺癌告别"低生存&
EGFR突变型患者在非小细胞肺癌中约占30%,在欧美患者中约占10%~20%,在亚洲患者中占比超过50%,是非小细胞肺癌的第二大致癌驱动因素。...
全球肿瘤医生网 2020-08-05
NK疗法开启抗癌新蓝海!首个晚期肺癌初战
EGFR突变型患者在非小细胞肺癌中约占30%,在欧美患者中约占10%~20%,在亚洲患者中占比超过50%,是非小细胞肺癌的第二大致癌驱动因素。...
全球肿瘤医生网 2020-08-05




![[field:title/]](/uploads/allimg/20200224/1-2002241I5262J.jpg)
![[field:title/]](/uploads/allimg/20200224/1-2002241I3461D.jpg)
![[field:title/]](/uploads/allimg/20200224/1-2002241H94LK.jpg)
![[field:title/]](/uploads/allimg/20200224/1-2002241HKW34.jpg)
![[field:title/]](/uploads/allimg/20200224/1-2002241H619327.jpg)
![[field:title/]](/uploads/allimg/20200224/1-2002241H34H52.jpg)
![[field:title/]](/uploads/allimg/20200224/1-2002241H22IH.jpg)
![[field:title/]](/uploads/allimg/20200224/1-2002241G93O18.jpg)

